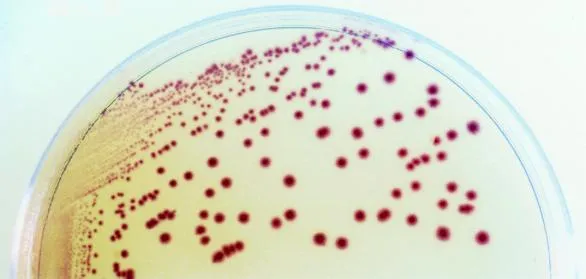
PCR: Cara Akurat Cek Penyakit Udang Vaname

Hingga kini, penyakit udang vaname masih menjadi salah satu penyebab utama kerugian massal di tambak. Langkah penting untuk menghindari kerugian tersebut adalah dengan deteksi penyakit yang akurat dan...
Hingga kini, penyakit udang vaname masih menjadi salah satu penyebab utama kerugian massal di tambak. Langkah penting untuk menghindari kerugian tersebut adalah dengan deteksi penyakit yang akurat dan sedini mungkin.
Hasil dari deteksi penyakit digunakan sebagai titik acuan dalam menentukan tindakan pencegahan di tambak udang. Berbagai tindakan untuk menekan penyebaran atau dampak penyakit, seperti pemberian probiotik dan feed additive, bergantung pada hasil deteksi ini.
Untuk menjalankan deteksi penyakit yang akurat, tentu harus ditunjang dengan sistem dan teknologi yang mutakhir. Oleh karena itu, alokasi investasi pada proses deteksi penyakit ini juga penting agar budidaya udang tetap produktif.
Salah satu patogen penyebab penyakit udang vaname yang dikhawatirkan petambak adalah Vibrio. Bakteri Vibrio adalah penyebab beberapa penyakit kronis pada udang vaname yang dapat menimbulkan kerugian masif.
Contohnya yaitu Vibrio parahaemolyticus, penyebab penyakit Acute Hepatopancreatic Disease (AHPND) pada udang. Menurut data dari The Fish Site, AHPND telah mencetak kerugian sebesar 11,58 miliar USD dan menyebabkan lebih dari 100.000 pekerjaan hilang di Thailand.
Dengan adanya deteksi penyakit yang akurat dan sedini mungkin, potensi kerugian dapat dihindari serta menjaga budidaya udang tetap berkelanjutan.
Beberapa metode untuk mendeteksi penyakit udang yang telah umum dilakukan yaitu menggunakan chromogenic agar dan Real-Time atau Quantitative Polymerase Chain Reaction (qPCR).
Cek Penyakit Udang Vaname dengan Chromogenic Agar
Chromogenic agar merupakan suatu substrat yang digunakan untuk kultur bakteri. Akan tetapi, chromogenic agar hanya memiliki kemampuan memunculkan warna tertentu terhadap suatu koloni bakteri.
Chromogenic agar mengandung bahan chromogenic yang akan mengeluarkan warna spesifik ketika distimulasi oleh aktivitas enzim tertentu. Enzim ini merupakan zat alami yang dikeluarkan oleh bakteri patogen. Dengan begitu, chromogenic agar dapat mendeteksi bakteri patogen dari enzim yang diekresikan.
Singkatnya, warna-warna yang muncul pada chromogenic agar tersebut memungkinkan petambak untuk mendeteksi patogen penyebab penyakit udang hanya dengan penglihatan mata saja.
Penggunaan chromogenic agar ini telah umum dilakukan untuk deteksi Vibrio pada udang vaname.
Berikut merupakan contoh penggunaan chromogenic agar untuk mendeteksi bakteri Vibrio.
Sumber: Improved Method for Detection of Vibrio parahaemolyticus in Seafood (2001)
Warna ungu pada chromogenic agar di atas muncul akibat aktivitas enzim spesifik yang dikeluarkan oleh Vibrio parahaemolyticus. Dengan begitu, dapat disimpulkan bahwa sampel terdeteksi mengandung bakteri Vibrio.
Cek Penyakit Udang Vaname dengan PCR
Istilah PCR mungkin telah sering terdengar pada masa pandemi lalu sebagai metode tes untuk mendeteksi infeksi penyakit COVID-19. Namun, metode ini juga dapat digunakan di berbagai bidang, termasuk perikanan.
PCR merupakan metode untuk mengidentifikasi materi genetik tertentu pada suatu sampel. Oleh karena itu, metode ini dapat dimanfaatkan untuk mengidentifikasi spesies patogen pada level molekuler.
Salah satu metode PCR yang banyak digunakan di tambak udang adalah real-time PCR atau qPCR. Metode ini tidak hanya mengidentifikasi spesies patogen, melainkan juga kelimpahan patogen yang mencerminkan tingkat penyebarannya pada udang.
Metode qPCR memiliki keunggulan dari PCR konvensional karena data hasil prosesnya dapat dilihat dalam bentuk grafik secara langsung. Hal ini berbeda dengan hasil PCR konvensional yang harus melalui proses elektroporasi terlebih dahulu.
Berikut merupakan contoh hasil proses deteksi Vibrio pada udang vaname menggunakan metode qPCR dan PCR konvensional.

Sumber: Deteksi Vibrio parahaemolyticus menggunakan Marka Gen PirA pada Udang Vaname (Litopenaeus vannamei) dengan Real Time PCR (2020)
Gambar di kiri menunjukkan hasil dari deteksi Vibrio pada udang vaname menggunakan qPCR berupa grafik yang dapat dianalisis langsung untuk mengetahui keberadaan bakteri Vibrio serta kuantitasnya.
Gambar di kanan menunjukkan hasil proses elektroforesis dari materi genetik Vibrio yang dicocokkan pada sampel untuk menentukan keberadaan bakteri Vibrio.
Perbandingan qPCR dengan Chromogenic Agar
Aplikasi qPCR memiliki beberapa keunggulan dari chromogenic agar dalam pengecekan penyakit, yakni pada tingkat akurasi dan durasi penggunaan.
Tingkat Akurasi
Berdasarkan hasil analisis pada level molekuler, metode qPCR memberikan hasil yang lebih akurat daripada chromogenic agar yang didasarkan pada aktivitas enzimatik.
Chromogenic agar masih dapat digunakan sebagai analisis sederhana untuk memberikan indikasi awal adanya penyakit udang vaname di suatu daerah. Namun, hasil dari chromogenic agar perlu dikonfirmasi lebih lanjut dan belum dapat digunakan sebagai acuan tindakan yang akan dilakukan.
Dengan metode qPCR, petambak dapat memastikan spesies patogen secara presisi sekaligus mengetahui estimasi kelimpahan patogen pada saat pengambilan sampel.
Selain itu, terdapat beberapa kemungkinan bias pada penentuan spesies dengan menggunakan chromogenic agar akibat pengaruh suhu dan kesamaan warna antar varietas
Hasil warna pada chromogenic agar rentan berubah akibat perubahan suhu, sehingga penentuan spesies penyakit menjadi tidak akurat.
Sebagai contoh pada deteksi Vibrio pada udang vaname, hasil warna yang keluar berpotensi berubah dari indikasi Vibrio parahaemolyticus (ungu muda) menjadi Vibrio harveyi (ungu tua).
Kemungkinan bias spesies juga terdapat pada perkiraan spesies dari hasil warna ungu muda yang muncul ini. Warna ungu muda yang muncul dapat disebabkan oleh bakteri Vibrio parahaemolyticus penyebab AHPND, Vibrio parahaemolyticus non-AHPND, serta Vibrio hepatarius.
Hal ini tentu menyebabkan hasil deteksi Vibrio pada udang vaname menjadi tidak akurat dalam mencegah AHPND.
Durasi Deteksi Penyakit
Proses deteksi penyakit udang vaname dengan qPCR relatif lebih cepat dibandingkan dengan chromogenic agar.
Durasi proses deteksi dengan qPCR hanya memakan waktu beberapa jam, yang lebih singkat dengan durasi chromogenic agar yang bisa lebih dari 1 hari. Hal ini disebabkan oleh prinsip chromogenic agar yang harus melalui proses inkubasi untuk menumbuhkan bakteri terlebih dahulu.
Chromogenic agar dapat memperlihatkan hasil warna setelah bakteri yang ditargetkan tumbuh dan membentuk koloni terlebih dahulu. Sedangkan, qPCR hanya perlu melalui proses ekstraksi materi genetik dan analisis dengan mesin qPCR.
Sebagai contoh, proses deteksi Vibrio pada udang vaname dengan menggunakan chromogenic agar diperkirakan dapat memakan waktu 18-24 jam untuk masa inkubasinya.
Cek Penyakit Tambak Anda bersama CeKolam
CeKolam menghadirkan layanan cek penyakit termasuk deteksi Vibrio pada udang vaname dengan teknologi Real-Time PCR yang akurat dan cepat.
CeKolam merupakan penyedia layanan deteksi penyakit tambak yang dipelopori oleh Nusantara Genetics atau Nusantics.
Nusantics sendiri telah dikenal sebagai penyedia layanan tes PCR selama masa pandemi yang dapat diandalkan. Sebanyak 8 juta produk Nusantics telah digunakan untuk mendeteksi virus COVID-19.

Sumber gambar: Nusantics
Dengan teknologi Real-Time PCR dari CeKolam, penyakit udang vaname dapat diketahui bahkan sebelum gejala pertama muncul. Keunggulan ini menjadikan Petambak dapat mengambil tindakan sebelum terjadi kerugian masif.
Bersama CeKolam dari Nusantics, deteksi penyakit lebih dini dan hindari kerugian hingga miliaran rupiah.
Cek layanannya di sini.
Sumber:
https://thefishsite.com/articles/yang-perlu-anda-ketahui-tentang-ems-ahpnd-dalam-budidaya-udang
https://www.ncbi.nlm.nih.gov/pmc/articles/PMC5355637/
https://www.ncbi.nlm.nih.gov/pmc/articles/PMC93376/
http://ejournal-balitbang.kkp.go.id/index.php/jra/article/view/8145/6741
https://www.labunlimited.co.uk/pdf/2054_en_2.pdf
Gunakan layanan digital marketing Minapoli secara mudah dengan menghubungi marketing@minapoli.com. Konsultasikan juga strategi marketing perusahaan Anda dengan Minapoli disini!

Ditulis oleh
Minapoli
Penulis
Pakar di bidang akuakultur dengan pengalaman lebih dari 15 tahun. Aktif berkontribusi dalam pengembangan industri perikanan Indonesia.
